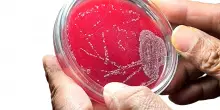

s

Cronaca
Il ’buco’ delle visite non pagate. L’Ausl deve riscuotere 10 milioni
01-06-2025, 07:50
L’azienda sanitaria della Romagna tra il 2018 e il 2024 ha recuperato appena il 3% dei crediti
CONTINUA A LEGGERE
9
0
0
Guarda anche
Il Resto del Carlino
Prende una infezione in ospedale e muore: l’Ausl deve pagare un milione e mezzo
Il Resto del Carlino

Ausl di Imola, il bilancio: il rosso sfiora gli 11 milioni di euro
Il Resto del Carlino
03:00
Rifiuta l’esame orale di maturità, un caso a Pesaro: “Ho letto il mio discorso”
Il Resto del Carlino
02:31
Doglie sui monti, Ginevra nasce in ambulanza
Il Resto del Carlino
02:23
Il Passante che verrà, tavolo tecnico a Roma. “Opere green confermate”
Il Resto del Carlino
02:22
Max Pezzali, oggi il concerto: in 85mila all’Autodromo. L’omaggio ad Ayrton
Il Resto del Carlino
02:12
Lauree ‘mutilate’, la svolta. L’intervento del ministero: una legge per la ‘sanatoria’
Il Resto del Carlino
02:00